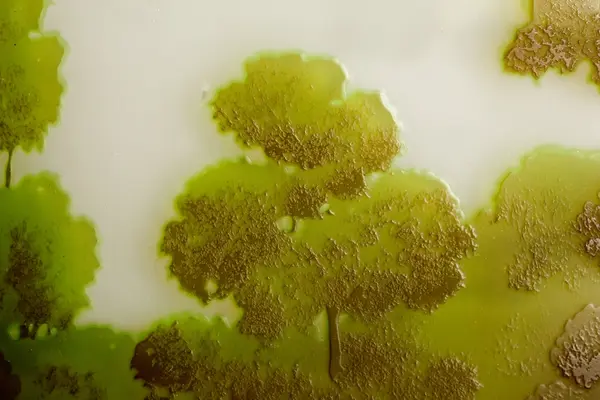

History
-
Produktion: 1900 - 1930
- Designer/FormgivareGallé, Emile (1846 - 1904)
- TillverkningsortFrankrike Nancy Meurthe-et-Moselle, Grand Est.
Förvärv: 1938
- Givare till museetLöfberg, Gustavsäker
Classification
License information
-
License
Attribution (CC BY)

- Photographer Ludwigsson, Jörgen
- Ägare av original Kulturparken Småland AB
Endast bildlicens. Avbildade föremål kan ha egen upphovsrätt.
Metadata
- Identifier M 12752
- Part of collection Föremål
- Owner of collection Kulturparken Småland/Smålands museum
- Institution Kulturparken Småland / Smålands museum
- Date published October 31, 2019
- Date updated February 9, 2026
- DIMU-CODE 021028436382
- UUID 4e559895-4484-45fc-90e3-3f243b21c973
- Tags

Add a comment or suggest edits
To publish a public comment on the object, select «Leave a comment». To send an inquiry directly to the museum, select «Send an inquiry».